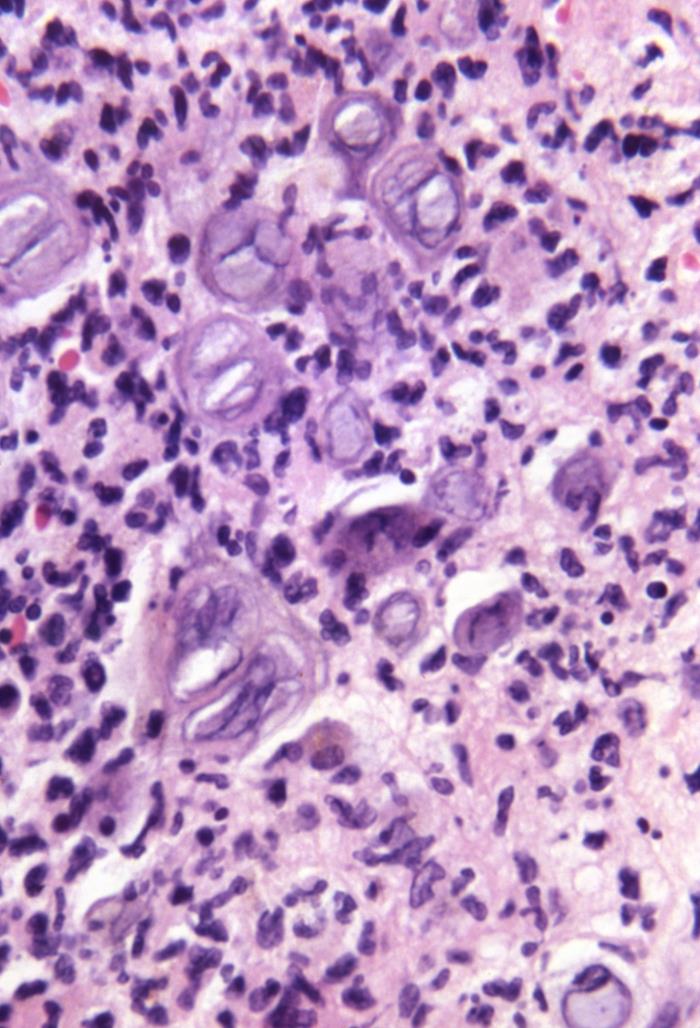
STD Management

Kyutis Clinic · Est. 1988 · Ikoyi, Lagos
Providing comprehensive clinical dermatology care with competence and compassion for over three decades.
About Us
Kyutis Clinic is a dermatology clinic providing comprehensive clinical care for diseases of the skin, hair and nails. Founded in 1988, we have built a reputation for excellence in dermatological treatment across Lagos and beyond.
Our clinic is run by a competent and friendly staff committed to providing the best possible dermatology care — combining clinical expertise with a warm, patient-centred approach.
2A Raymond Njoku Street
Ikoyi, Lagos, Nigeria
08023039815
02014541881
What We Treat
From routine skin consultations to advanced cosmetic procedures, our specialist team delivers clinical excellence across five core disciplines.

Diagnosis and treatment of a wide range of skin conditions including eczema, psoriasis, acne, rashes, and infections of the skin.
Confidential diagnosis and management of sexually transmitted diseases, with a sensitive and professional approach to patient care.

Surgical and cosmetic procedures for the skin, including mole removal, scar treatment, and aesthetic enhancement procedures.

Assessment and management of skin allergies, contact dermatitis, and hypersensitivity reactions with targeted treatment plans.

Light-based treatment for chronic skin conditions such as psoriasis, vitiligo, and eczema using controlled UV therapy.
Book a Visit
Fill in the form below and we will get back to you to confirm your appointment.